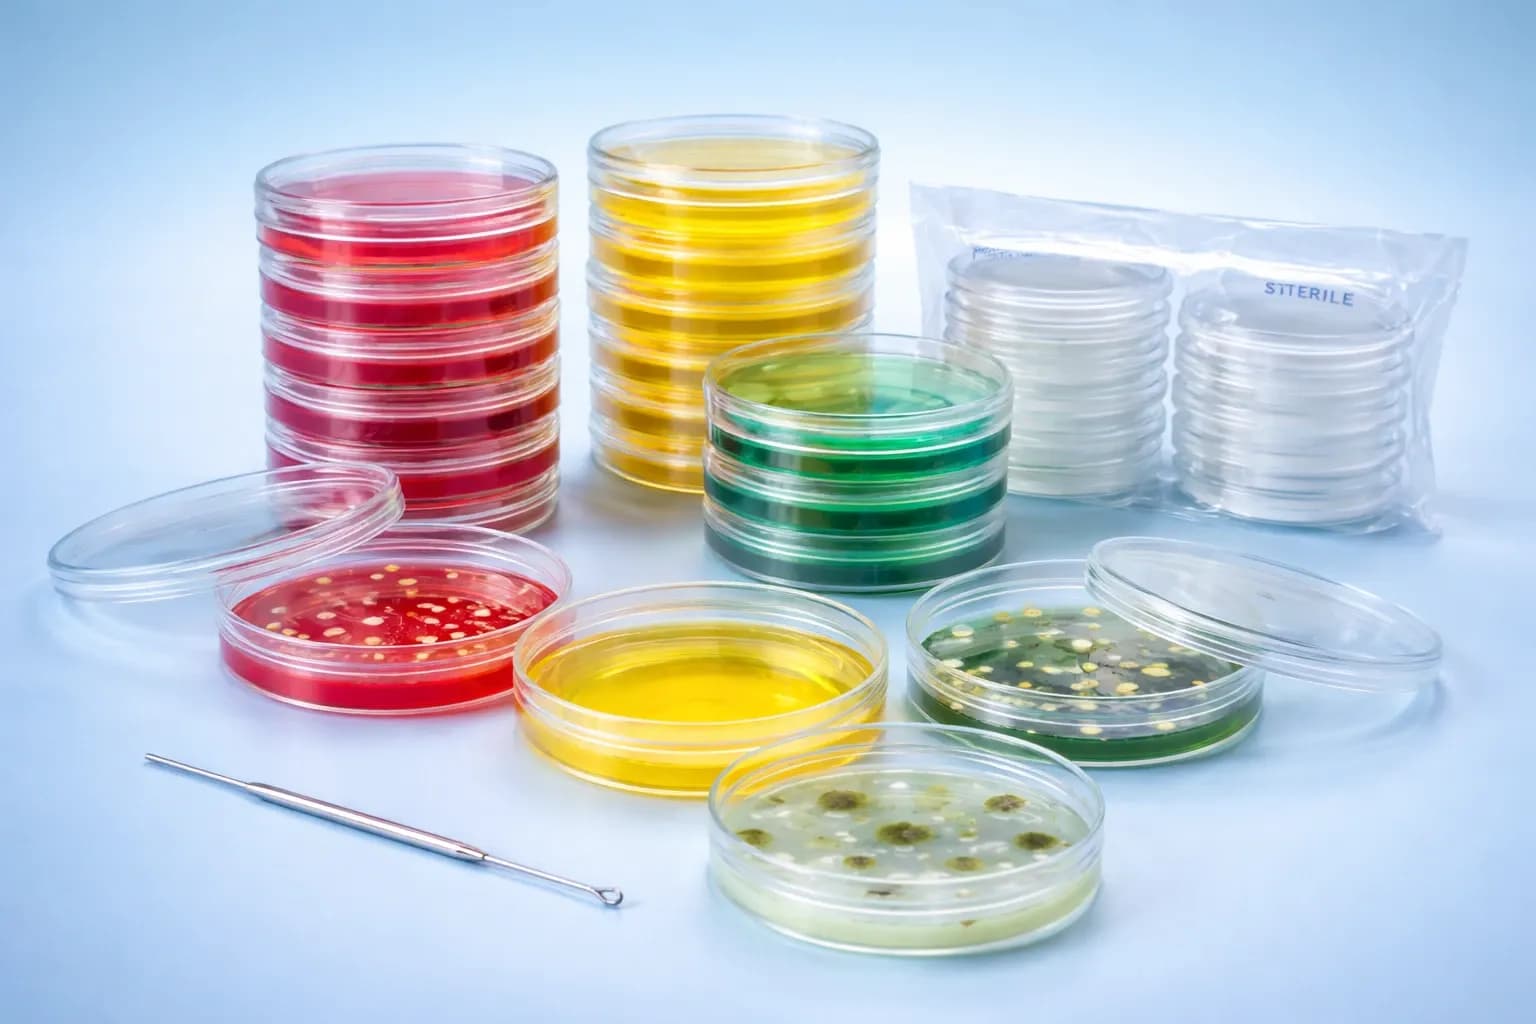
Petri Dishes

Our Products
Medigrid Health Care Private Limited
ISO 9001:2015 Certified Organisation
Medigrid Health Care Private Limited delivers professional healthcare supply solutions, diagnostic equipment, laboratory consumables, and technical support services to hospitals and laboratories with a focus on quality, reliability, and long-term partnerships.
Laboratory Consumables

Urine Containers

Blood Collection Tubes

RIA Vials & Test Tubes

Petri Dishes

Micro Centrifuge Tubes
ELISA Test Kits

HIV ELISA

HBsAg ELISA

Dengue ELISA

TSH / TPO ELISA

Tumor Markers ELISA
Laboratory Instruments

Urine Analysers

ESR & Electrolyte Analysers

Hematology Analyser with Reagents

Biochemistry Semi Auto Analyser

Fully Auto Biochemistry Analyser
Rapid Cards

HIV Rapid Card Test

HBsAg Rapid Test

Malaria Rapid Test

Dengue Rapid Test

Syphilis Rapid Card Test